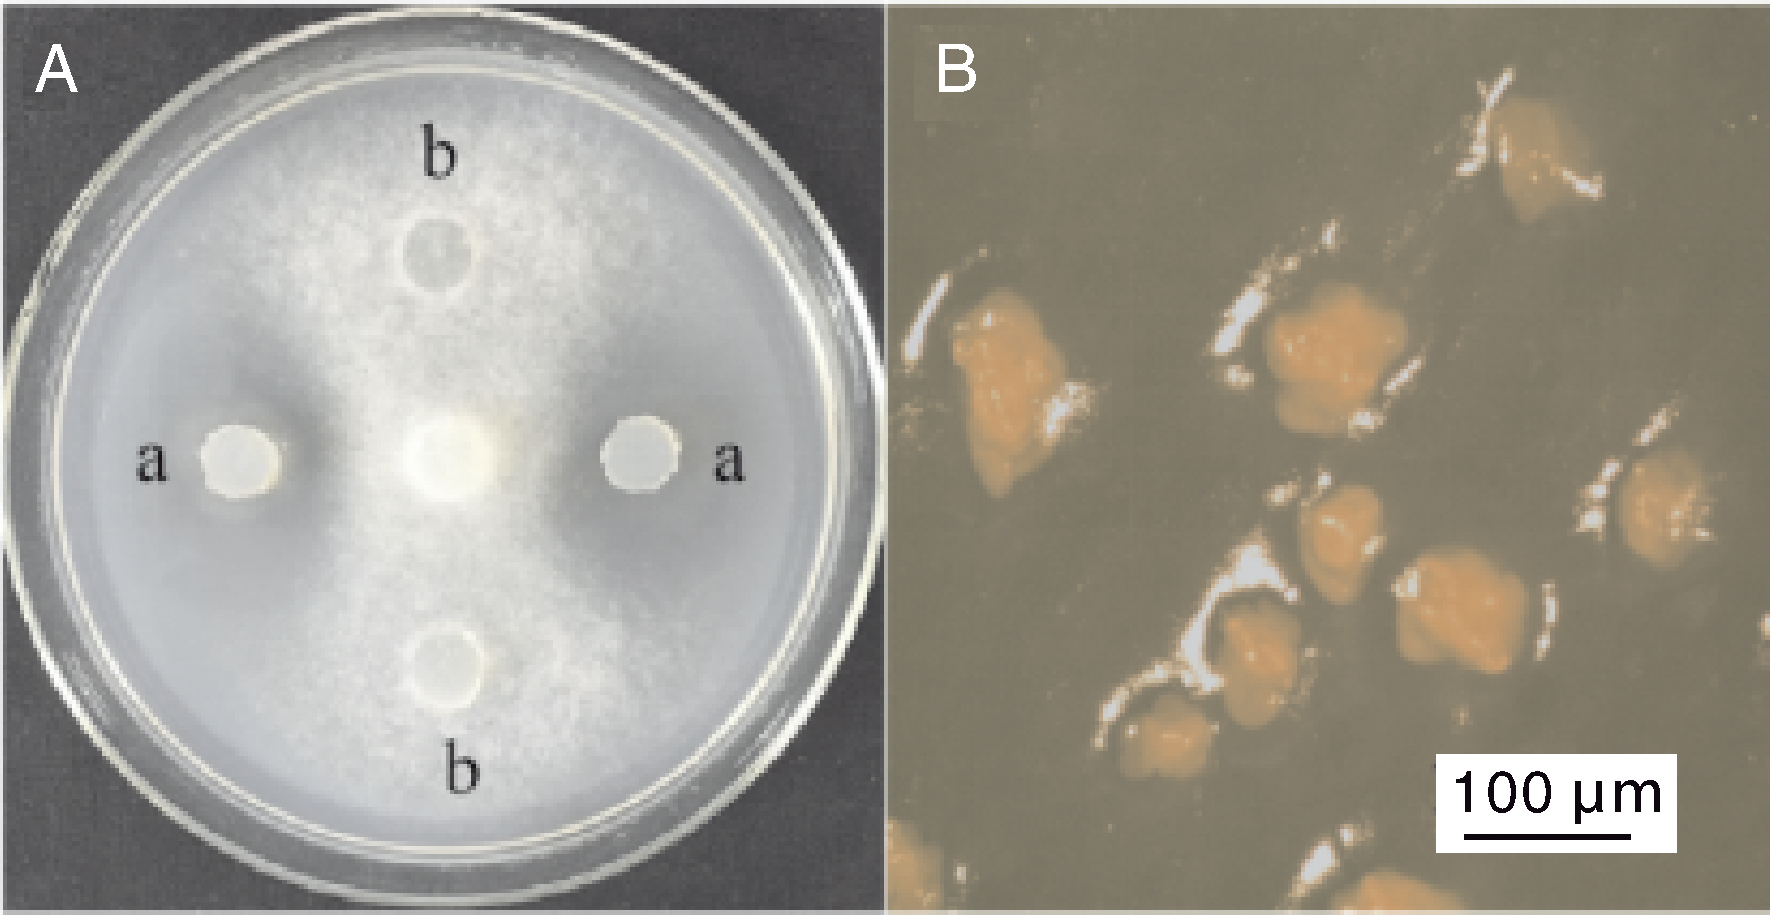

Acta Agriculturae Zhejiangensis ›› 2025, Vol. 37 ›› Issue (12): 2554-2562.DOI: 10.3969/j.issn.1004-1524.20241106
• Plant Protection • Previous Articles Next Articles
Isolation and identification of a myxobacterial strain against Phytophthora infestans and optimization of its fermentation conditions
ZHANG Yu( ), DING Yixiu, LI Junda, SHANG Shaojie, ZHAO Xiaojing, HOU Kexin, GAO Yandong, LIU Huirong*(
), DING Yixiu, LI Junda, SHANG Shaojie, ZHAO Xiaojing, HOU Kexin, GAO Yandong, LIU Huirong*( )
)
- College of Life Sciences, Inner Mongolia Agricultural University, Hohhot 010018, China
-
Received:2024-12-20Online:2025-12-25Published:2026-01-09
CLC Number:
Cite this article
ZHANG Yu, DING Yixiu, LI Junda, SHANG Shaojie, ZHAO Xiaojing, HOU Kexin, GAO Yandong, LIU Huirong. Isolation and identification of a myxobacterial strain against Phytophthora infestans and optimization of its fermentation conditions[J]. Acta Agriculturae Zhejiangensis, 2025, 37(12): 2554-2562.
share this article
Add to citation manager EndNote|Ris|BibTeX
URL: http://www.zjnyxb.cn/EN/10.3969/j.issn.1004-1524.20241106
| 水平 Level | 因素Factor | ||
|---|---|---|---|
| (A)温度 Temperature/℃ | (B)时间 Time/d | (C)NaCl质量分数 NaCl mass fraction/% | |
| 1 | 30 | 9 | 0 |
| 2 | 32 | 11 | 0.5 |
| 3 | 34 | 13 | 1.0 |
Table 1 Factors for the orthogonal experimental design of strain E12 fermentation conditions
| 水平 Level | 因素Factor | ||
|---|---|---|---|
| (A)温度 Temperature/℃ | (B)时间 Time/d | (C)NaCl质量分数 NaCl mass fraction/% | |
| 1 | 30 | 9 | 0 |
| 2 | 32 | 11 | 0.5 |
| 3 | 34 | 13 | 1.0 |
Fig.1 Antagonistic plate of the strain E12 against P. infestans and the fruiting bodies of strain E12 A, Plate assay showing the antagonistic activity of strain E12 against Phytophthora infestans; a, Mycelial plug of E12; b, Blank control (VY/2 medium); B, Morphology of the fruiting bodies of strain E12.

Fig.3 Inhibition zone diameter of the fermentation supernatant of strain E12 on different culture media Bars without the same lowercase letter indicate significant (p<0.05) differences. The same as below.
| 实验编号 No. | 因素 Factor | 抑菌圈直径 Inhibition zone diameter/mm | ||||
|---|---|---|---|---|---|---|
| A | B | C | 空白Blank | |||
| 1 | 3 | 2 | 3 | 1 | 0 | |
| 2 | 3 | 3 | 1 | 2 | 20.00±3.06 | |
| 3 | 2 | 1 | 3 | 2 | 0 | |
| 4 | 2 | 3 | 2 | 1 | 21.30±0.67 | |
| 5 | 2 | 2 | 1 | 3 | 26.00±1.15 | |
| 6 | 1 | 3 | 3 | 3 | 0 | |
| 7 | 1 | 1 | 1 | 1 | 12.00±2.00 | |
| 8 | 3 | 1 | 2 | 3 | 16.00±2.31 | |
| 9 | 1 | 2 | 2 | 2 | 18.00±3.06 | |
Table 2 Results of orthogonal experiment optimization
| 实验编号 No. | 因素 Factor | 抑菌圈直径 Inhibition zone diameter/mm | ||||
|---|---|---|---|---|---|---|
| A | B | C | 空白Blank | |||
| 1 | 3 | 2 | 3 | 1 | 0 | |
| 2 | 3 | 3 | 1 | 2 | 20.00±3.06 | |
| 3 | 2 | 1 | 3 | 2 | 0 | |
| 4 | 2 | 3 | 2 | 1 | 21.30±0.67 | |
| 5 | 2 | 2 | 1 | 3 | 26.00±1.15 | |
| 6 | 1 | 3 | 3 | 3 | 0 | |
| 7 | 1 | 1 | 1 | 1 | 12.00±2.00 | |
| 8 | 3 | 1 | 2 | 3 | 16.00±2.31 | |
| 9 | 1 | 2 | 2 | 2 | 18.00±3.06 | |
| 因素 | k1 | k2 | k3 | R |
|---|---|---|---|---|
| A | 10.00 | 16.00 | 12.00 | 6.00 |
| B | 9.30 | 14.60 | 14.00 | 5.30 |
| C | 19.30 | 18.70 | 0 | 19.30 |
| 空白Blank | 11.30 | 12.70 | 14.00 | 2.70 |
Table 3 Results of range analysis
| 因素 | k1 | k2 | k3 | R |
|---|---|---|---|---|
| A | 10.00 | 16.00 | 12.00 | 6.00 |
| B | 9.30 | 14.60 | 14.00 | 5.30 |
| C | 19.30 | 18.70 | 0 | 19.30 |
| 空白Blank | 11.30 | 12.70 | 14.00 | 2.70 |

Fig.5 Inhibition zone diameter of fermentation supernatants against Phytophthora infestans under different fermentation conditions 1, Fermentation condition optimized through the single-factor experiment; 2, Fermentation conditions optimized through the orthogonal experiment.

Fig.6 Inhibition zone diameter of the concentrated fermentation supernatant of strain E12 against Phytophthora infestans A, B, and C represent the concentrated fermentation supernatant without resin addition, the concentrated supernatant after resin filtration, and the concentrated resin eluate, respectively.
| [1] | 杜欣然, 王晶晶, 冉柒, 等. 黏细菌资源及其系统分类[J]. 微生物学通报, 2023, 50(7): 3104-3121. |
| DU X R, WANG J J, RAN Q, et al. Resources and taxonomy of myxobacteria: a review[J]. Microbiology China, 2023, 50(7): 3104-3121. (in Chinese with English abstract) | |
| [2] | WANG C Y, HU J Q, WANG D G, et al. Recent advances in discovery and biosynthesis of natural products from myxobacteria: an overview from 2017 to 2023[J]. Natural Product Reports, 2024, 41(6): 905-934. |
| [3] | 王春玲, 吕颖颖, 姚青, 等. 粘细菌资源挖掘与多相分类研究进展[J]. 微生物学通报, 2021(8): 2870-2880. |
| WANG C L, LYUY Y, YAO Q, et al. Research progress in resources mining and polyphase classification of myxobacteria[J]. Microbiology China, 2021(8): 2870-2880. (in Chinese with English abstract) | |
| [4] | WANG T H, LV J L, XU J P, et al. The catalase-peroxidase PiCP1 plays a critical role in abiotic stress resistance, pathogenicity and asexual structure development in Phytophthora infestans[J]. Environmental Microbiology, 2023, 25(2): 532-547. |
| [5] | BERINDEAN I V, TAOUTAOU A, RIDA S, et al. Modern breeding strategies and tools for durable late blight resistance in potato[J]. Plants, 2024, 13(12): 1711. |
| [6] | 祝菊澧, 梁静思, 王伟伟, 等. 马铃薯致病疫霉研究进展[J]. 微生物学通报, 2020, 47(3): 952-966. |
| ZHU J L, LIANG J S, WANG W W, et al. Research progress in Phytophthora infestans, pathogen of potato late blight[J]. Microbiology China, 2020, 47(3): 952-966. (in Chinese with English abstract) | |
| [7] | 丁一秀. 鄂尔多斯高原地区粘细菌的分离鉴定及其拮抗致病疫霉活性的初步分析[D]. 呼和浩特: 内蒙古农业大学, 2017. |
| DING Y X. Isolation and identification of myxobacteria from Ordos Plateau area and preliminary analysis of their antibiotic activities against Phytophthora infestans[D]. Hohhot: Inner Mongolia Agricultural University, 2017. (in Chinese with English abstract) | |
| [8] | 武志华, 郭维维, 董晔, 等. 抗马铃薯晚疫病菌的粘细菌菌株X6-Ⅱ-1的分离鉴定、拮抗活性及发酵条件的优化[J]. 农业生物技术学报, 2018, 26(9): 1467-1479. |
| WU Z H, GUO W W, DONG Y, et al. Isolation and identification of myxobacterial strain X6-Ⅱ-1 resistant to Phytophthora infestans and its antibiotic activity and optimal fermentation condition[J]. Journal of Agricultural Biotechnology, 2018, 26(9): 1467-1479. (in Chinese with English abstract) | |
| [9] | 余培斌, 杜晶, 陈建新. 高温好氧堆肥过程中芽孢杆菌的筛选、鉴定及应用[J]. 食品与发酵工业, 2020, 46(12): 199-205. |
| YU P B, DU J, CHEN J X. Study on screening and identification of Bacillus in the process of high-temperature aerobic composting and its application[J]. Food and Fermentation Industries, 2020, 46(12): 199-205. (in Chinese with English abstract) | |
| [10] | DWORKIN M. Recent advances in the social and developmental biology of the myxobacteria[J]. Microbiological Reviews, 1996, 60(1): 70-102. |
| [11] | GARRITY G M, BELL J A, LILBURN T G. Bergey’s manual of systematic bacteriology[M]. New York: Springer-Verlag, 2004. |
| [12] | 任兴波, 武志华, 崔海辰, 等. 致病疫霉拮抗菌株YR-7的分离鉴定及其活性物质[J]. 微生物学通报, 2016, 43(7): 1513-1523. |
| REN X B, WU Z H, CUI H C, et al. Isolation and identification of the strain YR-7 against Phytophthora infestans and study on its antibiotic substances[J]. Microbiology China, 2016, 43(7): 1513-1523. (in Chinese with English abstract) | |
| [13] | 肖春芳. 西南地区马铃薯对晚疫病的抗性评价及抗病相关机制的解析[D]. 武汉: 华中农业大学, 2024. |
| XIAO C F. Evaluation of potato resistance to late blight in southwest China and dissection of disease resistance mechanisms[D]. Wuhan: Huazhong Agricultural University, 2024. (in Chinese with English abstract) | |
| [14] | 张欣杰, 宋文睿, 陈汉, 等. 马铃薯晚疫病化学防控现状与展望[J]. 中国植保导刊, 2021, 41(6): 33-39. |
| ZHANG X J, SONG W R, CHEN H, et al. Status and prospects of chemical prevention and control of potato late blight[J]. China Plant Protection, 2021, 41(6): 33-39. (in Chinese with English abstract) | |
| [15] | WANG Y X, LI M S, YING J H, et al. High-efficiency green management of potato late blight by a self-assembled multicomponent nano-bioprotectant[J]. Nature Communications, 2023, 14: 5622. |
| [16] | CAULIER S, GILLIS A, COLAU G, et al. Versatile antagonistic activities of soil-borne Bacillus spp. and Pseudomonas spp. against Phytophthora infestans and other potato pathogens[J]. Frontiers in Microbiology, 2018, 9: 143. |
| [17] | 张玉. 粘细菌B25-Ⅰ-3菌株制剂对马铃薯晚疫病的田间防治效果[D]. 呼和浩特: 内蒙古农业大学, 2023. |
| ZHANG Y. Field control effect of preparation of myxobacterium strain B25-Ⅰ-3 on potato late blight[D]. Hohhot: Inner Mongolia Agricultural University, 2023. (in Chinese with English abstract) | |
| [18] | 武志华, 赵璞钰, 丁一秀, 等. 致病疫霉拮抗菌株B25-Ⅰ-3的鉴定及其次级代谢产物[J]. 微生物学通报, 2020, 47(11): 3586-3599. |
| WU Z H, ZHAO P Y, DING Y X, et al. Identification and secondary metabolites of strain B25-Ⅰ-3 against Phytophthora infestans[J]. Microbiology China, 2020, 47(11): 3586-3599. (in Chinese with English abstract) | |
| [19] | BADER C D, PANTER F, MÜLLER R. In depth natural product discovery: myxobacterial strains that provided multiple secondary metabolites[J]. Biotechnology Advances, 2020, 39: 107480. |
| [20] | 封成玲, 刘洋, 贾紫伟, 等. 产酶溶杆菌L-43合成抗菌肽的发酵工艺优化[J]. 食品与发酵工业, 2022, 48(19): 196-203. |
| FENG C L, LIU Y, JIA Z W, et al. Optimization of fermentation process for production of antimicrobial peptides with Lysobacter enzymogenes L-43[J]. Food and Fermentation Industries, 2022, 48(19): 196-203. (in Chinese with English abstract) | |
| [21] | 宋亚迪, 郭婷, 修志君, 等. 马铃薯疮痂病生防链霉菌菌株PBSH9发酵条件优化[J]. 作物杂志, 2024(5): 255-262. |
| SONG Y D, GUO T, XIU Z J, et al. Optimization of fermentation conditions for the biocontrol Streptomyces strain PBSH9 against potato scab disease[J]. Crops, 2024(5): 255-262. (in Chinese with English abstract) | |
| [22] | 刘晓霞, 伏漪, 王宗成, 等. 立枯丝核菌拮抗菌枯草芽孢杆菌ATCC 6051发酵条件优化及抑菌物质分析[J]. 核农学报, 2024, 38(7): 1326-1334. |
| LIU X X, FU Y, WANG Z C, et al. Optimizing fermentation conditions and inhibitory substance analysis of Bacillus subtilis ATCC 6051 antagonistic to Thanatephorus[J]. Journal of Nuclear Agricultural Sciences, 2024, 38(7): 1326-1334. (in Chinese with English abstract) | |
| [23] | 白雪莹, 韩剑, 孙博源, 等. 梨火疫病和梨腐烂病生防潜力粘细菌的筛选鉴定及室内防效评价[J]. 中国生物防治学报, 2023, 39(6): 1384-1397. |
| BAI X Y, HAN J, SUN B Y, et al. Screening and identification of biocontrol potential myxobacteria strains against fire blight and pear canker diseases and evaluation of indoor control efficacy[J]. Chinese Journal of Biological Control, 2023, 39(6): 1384-1397. (in Chinese with English abstract) | |
| [24] | 尚少杰. 菌株CF-9-D抗肿瘤活性物质的分离鉴定及其代谢组与基因组分析[D]. 呼和浩特: 内蒙古农业大学, 2023. |
| SHANG S J. Isolation and identification of antitumor active substances from the strain CF-9-D and analysis of its metabolome and genome[D]. Hohhot: Inner Mongolia Agricultural University, 2023. (in Chinese with English abstract) | |
| [25] | SHARMA A, KUMAR A, BABU V, et al. Myxobacteria from animal dung pellets collected from northwestern Himalayas: a new source of di-isobutyl phthalate[J]. Journal of Basic Microbiology, 2022, 62(2): 162-173. |
| [26] | MOELLER M, NORRIS M D, PLANKE T, et al. Scalable syntheses of methoxyaspartate and preparation of the antibiotic cystobactamid 861-2 and highly potent derivatives[J]. Organic Letters, 2019, 21(20): 8369-8372. |
| [27] | WANG Y Y, BEGLEY T P. Mechanistic studies on CysS: a vitamin B12-dependent radical SAM methyltransferase involved in the biosynthesis of the tert-butyl group of cystobactamid[J]. Journal of the American Chemical Society, 2020, 142(22): 9944-9954. |
| [28] | 任兴波, 张子良, 赵璞钰, 等. 马铃薯晚疫病菌拮抗粘细菌YR-35的分离鉴定及其代谢产物稳定性[J]. 中国生物防治学报, 2016, 32(3): 379-387. |
| REN X B, ZHANG Z L, ZHAO P Y, et al. Isolation and identification of the strain YR-35 resistant to Phytophthora infestans and its metabolites[J]. Chinese Journal of Biological Control, 2016, 32(3): 379-387. (in Chinese with English abstract) | |
| [29] | HOFFMANN T, KRUG D, BOZKURT N, et al. Correlating chemical diversity with taxonomic distance for discovery of natural products in myxobacteria[J]. Nature Communications, 2018, 9: 803. |
| [30] | BERLEMAN J E, KIRBY J R. Deciphering the hunting strategy of a bacterial wolfpack[J]. FEMS Microbiology Reviews, 2009, 33(5): 942-957. |
| [31] | YE X F, LI Z K, LUO X, et al. A predatory myxobacterium controls cucumber fusarium wilt by regulating the soil microbial community[J]. Microbiome, 2020, 8(1): 49. |
| [1] | YI Ming, SUN Hong, SHEN Qi, TANG Jiangwu. Research progress on ectopic fermentation system in treatment of fecal residue and waste water of livestock and poultry [J]. Acta Agriculturae Zhejiangensis, 2025, 37(6): 1390-1396. |
| [2] | DU Song, TANG Tao, CHENG Xi, ZHAO Xueping, ZHANG Chunrong, LIANG Xiaoyu, WANG Meng, ZHANG Zhen, LI Yongcheng, ZHANG Chenghui. Exploring the degradation and soil enzyme impact of pyroxasulfone and its main metabolites in soils [J]. Acta Agriculturae Zhejiangensis, 2025, 37(4): 847-857. |
| [3] | LU Nanyang, ZHAO Tinglei, ZHOU Ying, YAO Yanlai, LI Penghao, HONG Chunlai, ZHU Weijing, HONG Leidong, ZHANG Tao, ZHU Fengxiang. Study on bioconversion process of gibberellin fermentation residue with fly maggots (Lucilia sericata) [J]. Acta Agriculturae Zhejiangensis, 2025, 37(4): 901-908. |
| [4] | XIA Si, FANG Xiangjun, WU Weijie, LIU Ruiling, CHEN Huizhi, NIU Ben, GAO Haiyan. Preparation of fermented Chinese bayberry (Myrica rubra) pulp and its functional activity and flavor quality [J]. Acta Agriculturae Zhejiangensis, 2025, 37(3): 667-678. |
| [5] | WU Jiaqi, ZHU Xueming, BAO Jiandong, WANG Caoyi, ZHOU Xiaoyu, LI Lin, LIN Fucheng. Research progress on biological control of rice blast [J]. Acta Agriculturae Zhejiangensis, 2025, 37(3): 736-744. |
| [6] | GAO Qiang, WANG Lili, ZHANG Jianlong, YANG Bo, LI Feng, ZHU Xianzhi, LIU Aixin, HAN Chao, TIAN Lei. Screening and identification of Bacillus altitudinis strain CY1 and its control effects against tobacco black shank [J]. Acta Agriculturae Zhejiangensis, 2025, 37(2): 405-416. |
| [7] | YANG Xueyu, NIU Li, TAN Lin, DENG Yulian, BAO Qiang, HU Qiulong. Optimization of the culture conditions of Bacillus subtilis subsp. inaquosorum kc-16 [J]. Acta Agriculturae Zhejiangensis, 2025, 37(12): 2563-2573. |
| [8] | ZHOU Maocuo, LU Jianxiong, GUO Xiaonong, FENG Yulan, CHAI Weiwei, GAO Pengfei. Optimization of quinoa straw fermentation process based on response surface methodology [J]. Acta Agriculturae Zhejiangensis, 2024, 36(9): 2020-2030. |
| [9] | ZHANG Ni, TAO Wenyang, LUO Mengfan, ZHOU Wanyi, ZHENG Xiaojie, LI Yanpo, JIN Huoxi, YANG Ying. Effects of enzyme-assisted extraction on composition and gut microbiota regulation function of Dendrobium officinale polysaccharide [J]. Acta Agriculturae Zhejiangensis, 2024, 36(9): 2099-2109. |
| [10] | LI Shuyan, JIAO Ting, QI Shuai, ZHANG Xia, WANG Huning, ZHAO Shengguo. In vitro study on effects of isochlorogenic acid supplementation in sheep diets on nutrient digestion and rumen fermentation [J]. Acta Agriculturae Zhejiangensis, 2024, 36(8): 1753-1763. |
| [11] | LIU Wenwen, HU Lianqing, ZHOU Wanhai, WEI Qin, FENG Ruizhang, ZHAO Xin, CHE Litao, CHEN Jinyu. Effects of different contents of Camphora longepaniculata leaves in diets on intestinal pH, cecal fermentation and cecal microbiota of meat rabbits [J]. Acta Agriculturae Zhejiangensis, 2024, 36(6): 1279-1289. |
| [12] | ZHANG Yue, CHEN Hui, ZHENG Yadan, YANG Peng, KE Zhigang, DAI Yangzhang, JIN Youding, DING Yuting, LIU Shulai. Quality changes of wine-lees mussel during wine-lees pickling process [J]. Acta Agriculturae Zhejiangensis, 2024, 36(2): 416-423. |
| [13] | GONG Na, LIU Guoli, CHEN Xun, MA Xiaoying, ZHAO Ying, XIAO Jun. Identification of a wild strain of Pleurotus pulmonarius and optimization of its liquid fermentation culture medium [J]. Acta Agriculturae Zhejiangensis, 2024, 36(11): 2535-2545. |
| [14] | LI Yanan, YE Wenxing, ZHU Xiangde, CHEN Lin, XU Xiaofeng, ZHANG Lili. LC-MS/MS-based study on effect of rice straw instead of partial corn silage on plasma metabolites of dairy cows [J]. Acta Agriculturae Zhejiangensis, 2023, 35(2): 266-274. |
| [15] | HE Yu, LYU Weiguang, LI Shuangxi, ZHENG Xianqing, ZHANG Hanlin, ZHANG Juanqin, ZHANG Haiyun, BAI Naling, LIU Shanliang. Effects of γ-polyglutamic acid fermentation broth on growth of pakchoi and utilization rate of nitrogen and phosphorus fertilizer [J]. Acta Agriculturae Zhejiangensis, 2023, 35(2): 329-337. |
| Viewed | ||||||
|
Full text |
|
|||||
|
Abstract |
|
|||||



